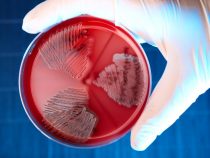

Už bábätká sa učia jazyk
Keď bábätká hľadia na hovoriaceho človeka, nevnímajú iba zvuky, ale učia sa aj to, ako sa vytvárajú. Podľa vedcov z Western Sydney University v Austrálii sa deti učia jazyk už vo veku štyroch mesiacov, dlho predtým, ako sa u nich začne proces zvaný percepčné naladenie,… pokračuj